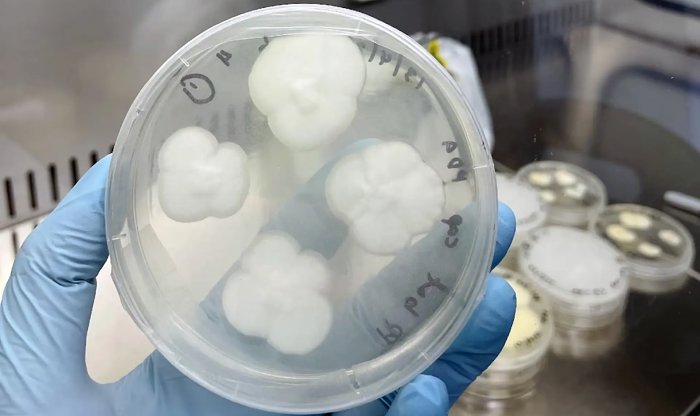
Грибки могут спасти человечество от надвигающейся пластиковой катастрофы

Грибки могут спасти человечество от надвигающейся пластиковой катастрофы
Исследователи из Сиднейского университета разработали метод утилизации полипропилена при помощи грибков. Эти организмы используют мощные ферменты, при помощи которых могут расщеплять множество материалов, чтобы затем поглотить их молекулы. Сложность в условиях процедуры – у всех грибков разные предпочтения и возможности.
Полипропилен является главным компонентом пластиковых отходов, потому что он быстро загрязняется, а потому практически не подлежит переработке. Из порядка 75 млн тонн производимого в мире за год полипропилена перерабатывается менее 1 %. В мировых реках накопилось уже 109 млн тонн этого пластика, а в морях 30 млн тонн, что сопоставимо с массой живущей там рыбы.
Австралийские ученые в ходе экспериментов остановили выбор на грибках видов Aspergillus terreus и Engyodontium album. Из множества способов предварительной обработки полипропилена — а без нее грибки его поглощать не могут — наиболее эффективными оказались нагрев и облучение ультрафиолетом. В результате грибки за 30 дней расщепили и поглотили 21 % массы полипропилена.
Теперь ученые хотят выяснить, какие биохимические процессы происходят при расщеплении полипропилена грибками. Если удастся в этом разобраться, появится возможность воссоздать процесс в искусственной среде — а потом и масштабировать до промышленного уровня. Это поможет справиться с катастрофическим загрязнением экосферы планеты пластиком.

Comments are closed.